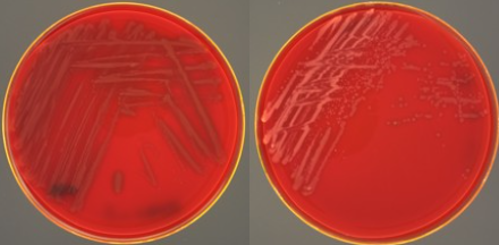

Det store spennet i varianter av Moritella viscosa gjør diagnostikk og arbeid med bakterien utfordrende. Gjennom flere år er det gjort mange undersøkelser av isolater med flere ulike analysemetoder. Under blir det gitt en oppsummering av de to mest benyttede metodene for karakterisering av bakterien.
Pharmaq Analytiq tilbyr bakteriologiske analyser, og har opplevd en økning i innsendelser fra anlegg med sårutfordringer de senere årene. Dersom det er M. viscosa til stede i innsendt materiale vil man ved hjelp av visuell undersøkelse av bakteriekoloniene kunne si om det er viskøse eller ikke-viskøse bakterier til stede. Videre analyseres koloniene ved hjelp av PCR for å bestemme om det er klassiske eller variante M. viscosa-isolater (Bilde 1 og 2). Basert på disse analysene kan man bestemme om isolatene som er til stede er for eksempel viskøse «variante» eller ikke-viskøse «klassiske» isolater.
Bilde 1 og 2 – Til venstre ses variant Moritella viscosa med grålige kolonier. Til høyre klassisk M. viscosa med hvite kolonier
MLVA-analyse og klonal komplekser
I tillegg til denne analysemetoden har Veterinærinstituttet (VI) utviklet en metode for MLVA-analyse (Multiple Loci VNTR Analysis) av M. viscosa-isolater fra felt. Seniorforsker i VI, Snorre Gulla forklarer nærmere om deres metode.
- MLVA er en metode som er velegnet til å kartlegge slektskap blant ulike stammer innen en bakterieart. Dette skjer ved at man sammenligner en spesiell type genetiske markører kalt mikrosatelitter eller VNTR. Disse markørene inneholder små repeterende områder som gjerne endres svært raskt i et evolusjonært perspektiv. Metoden er derfor best egnet til å sammenligne nært beslektede organisme, og en MLVA-analyse etablert for én art vil som regel ikke kunne brukes på andre arter.

Bilde 3 – Seniorforsker Snorre Gulla ved Veterinærinstituttet.
Gulla forteller videre at MLVA-analysen har identifisert flere stammer av bakterien, og at de ser ut til å være tilpasset ulike fiskearter.
- MLVA-analysen for M. viscosa har vist at det forekommer minst tre spesifikke stammer, eller klonalkomplekser, av denne bakterien som er tilpasset laks. Klonalkompleks (KK) er et begrep som brukes med henvisning til en større gruppe av svært nært beslektede isolater som deler identisk eller svært lik MLVA-profil. Det finnes også andre stammer av M. viscosa som ser ut til å være tilpasset andre fiskearter, sier Gulla.
Ifølge forskeren er fordelene ved MLVA-analysen at den er relativt enkel å utføre, og den produserer enkle data som lett lar seg sammenligne på tvers av laboratorier og kjøringer. Hvis man da har tilgang på en stor database av historiske MLVA-typede isolater vil man enkelt kunne plassere nye isolater inn i en historisk epidemiologisk kontekst, slik som et slektskapstre.
- Ved å kjøre MLVA på isolater fra et vintersårutbrudd vil man få svar på hvilke stammer som er til stede. Det er ikke uvanlig å påvise flere ulike stammer fra samme utbrudd, og heller ikke på samme fisk, slik at påvisning av én stamme utelukker ikke nødvendigvis tilstedeværelse av andre stammer, forteller Gulla.
I Norge har man de siste årene hovedsakelig funnet to av de tre laksespesifikke stammene, og disse to stammene kalles klonal kompleks 1 (KK1) og klonal kompleks 3 (KK3). KK1 tilsvarer såkalt «klassisk» M. viscosa. Selv om «klassiske» isolater normalt sett hører til i KK1 og «variante» ofte hører til i KK3, kan ikke den tidligere beskrevne analysemetoden fra Pharmaq Analytiq bestemme hvilket klonal kompleks isolatet hører hjemme i da dette krever at man har MLVA-profilen til isolatet.
Selv om MLVA er enkel å utføre, og gir god innsikt når det gjelder genetisk slektskap innad i en art, så har den noen begrensninger.
- De fenotypiske egenskapene hos isolater tilhørende samme klonalkompleks vil ofte være nokså like, men dette er ikke alltid tilfelle. For eksempel vil genetisk rekombinasjon på tvers av klonalkomplekser kunne resultere i fenotypiske egenskaper som ikke følger samme mønster som slektskapstreet, sier Gulla.
Et eksempel på fenotypiske ulikheter innen et klonalkompleks finnes i klonalkompleks 1. Her finner vi både viskøse og ikke-viskøse «klassiske» isolater. Serologiske analyser har vist at disse isolatene ikke bare har ulik viskositet, men også forskjellige serologiske egenskaper.
Avslutningsvis forteller Gulla at de har forskningsprosjekter der MLVA benyttes.
- Veterinærinstituttet leder et pågående forskningsprosjekt finansiert av FHF der ett av hovedmålene er, ved hjelp av helgenomsekvensering, å identifisere hvilke egenskaper ved KK1, KK2 og KK3 som gjør disse såpass godt tilpasset laks.
Arbeidet med M. viscosa de siste årene viser at det store spennet i varianter av bakterien gjør diagnostikk utfordrende. Pharmaq Analytiq benytter visuell undersøkelse og PCR-analyser for å skille mellom viskøse og ikke-viskøse, samt klassiske og variante isolater av bakterien. Veterinærinstituttets utvikling av MLVA-analysen har gjort det mulig å kartlegge genetisk slektskap mellom ulike isolater, som har ført til identifikasjon av klonalkomplekser tilpasset ulike fiskearter. Til tross for MLVA-analysens fordeler er det begrensninger knyttet til fenotypiske variasjoner innenfor klonalkomplekser.
Kilder:
https://www.sciencedirect.com/science/article/pii/S1050464823007921
https://onlinelibrary.wiley.com/doi/full/10.1111/jfd.13766https://www.fhf.no/prosjekter/prosjektbasen/901838/
PHARMAQ er verdens ledende selskap innen vaksiner og innovasjon rettet mot akvakulturnæringen og er en del av Zoetis, verdens ledende selskap innen dyrehelse. Våre innovative fiskehelseløsninger inkluderer et bredt spekter som fiskevaksiner, terapiprodukter, vaksinasjonsmaskiner inkludert servicetjenester, forskning og analyser. Selskapet leverer miljøvennlige, trygge og effektive helseprodukter til den globale akvakulturnæringen ved hjelp av målrettet forskning og engasjerte medarbeidere. Produksjon, administrasjon, forskning og utvikling ligger i Norge og med global virksomhet i kommersielle oppdrettsmarkeder har PHARMAQ rundt 375 medarbeidere. Konsernets produkter markedsføres i Europa, Nord- og Sør-Amerika samt i Asia. For mer informasjon, se selskapets hjemmeside: www.pharmaq.com. Personvernerklæring Erklæring om informasjonskapsler (cookies) Bruksvilkår
Copyright © 2020 Zoetis LLC. Alle rettigheter forbeholdt.